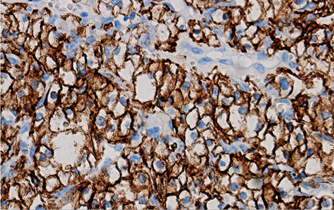

#BMC-001
BACKGROUND
Carbonic anhydrase IX (CAIX) is a hypoxia-inducible enzyme that plays a crucial role in regulating pH in the tumor microenvironment [Ref. 1]. CA IX expression is stronly associated with cancer phenotype and is present in a broad range of human tumors. It serves as a reliable marker of hypoxia, correlates with tumor aggressiveness, response to therapy and prognosis, and aids in the differentiation and diagnosis of certain cancer types, while also being a potential target for imaging and therapeutic strategies. Detection of CA IX in various cancer models can also advance research of tumor biology and the development of novel anti-cancer therapies.
FEATURES AND KEY BENEFITS
- Mab M75 recognizes repetitive linear epitope in the N-terminal PG region of the CA IX protein. It is suitable for detection of CA IX in FFPE specimens (incl. those archived for several years) and fresh-frozen human tissues as well as in fixed and fresh cells of human cell lines using the following immunodetection methods: immunohistochemistry, immunocytochemistry, Western blotting, ELISA, FACS and immunoprecipitation. M75 Mab was used in about 40% of studies related to CA IX detection in various patients’ tissue specimens and is superior to other available antibodies [for more details, see Ref. 2].
AVAILABLE
for non-exclusive licencing
or for research collaboration
REFERENCES
[1] Pastorekova S, Gillies RJ. The role of carbonic anhydrase IX in cancer development: links to hypoxia, acidosis, and beyond. Cancer Metastasis Rev. 2019 Jun;38(1-2):65-77. doi: 10.1007/s10555-019-09799-0.
[2] Takacova M, Kajanova I, Kolarcikova M, Lapinova J, Zatovicova M, Pastorekova S. Understanding metabolic alterations and heterogeneity in cancer progression through validated immunodetection of key molecular components: a case of carbonic anhydrase IX. Cancer Metastasis Rev. 2021 Dec;40(4):1035-1053. doi: 10.1007/s10555-021-10011-5.
CONTACT

Fig. shows immunohistochemical staining of tumor tissue section with M75 MAb (upper image), detection of CA IX protein in cell lines by Western blotting (middle) and immunoflurescence analysis of transfected cells with constitutive expression of CA IX protein on the plasma membrane (lower image).
Back